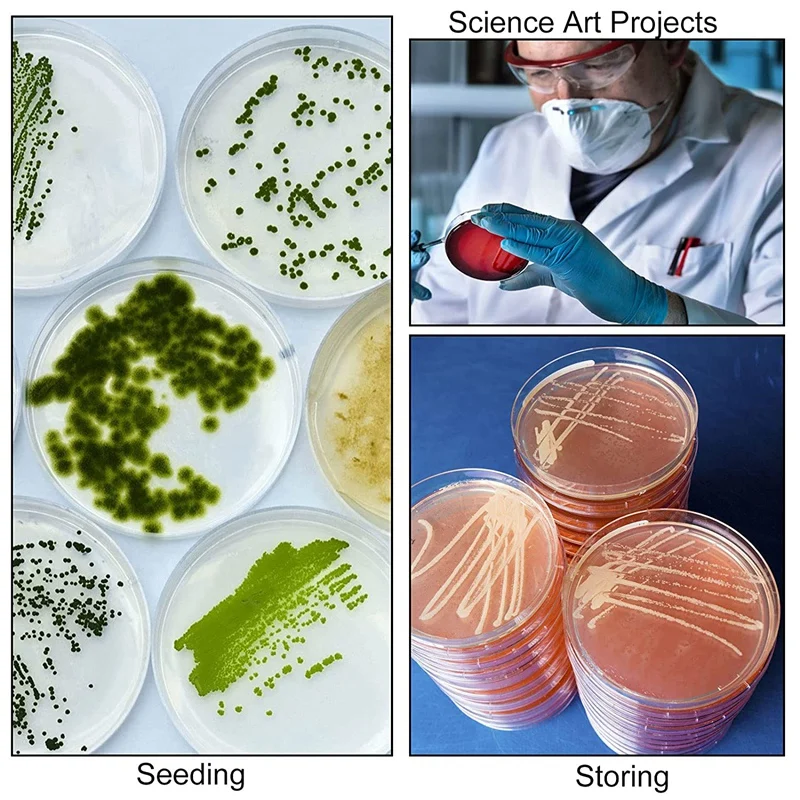
thumb

Набор чашек Петри с крышками, Набор чашек Петри с пластиковыми переносными пипетками 100 (3 мл), набор для школы, научных ярмарк

sku: 1005003440382413
ACCORDING TO OUR RECORDS THIS PRODUCT IS NOT AVAILABLE NOW
$10.49
Shipping from: China
Price history chart & currency exchange rate
Customers also viewed

$3.27
NEW2023 Rainfall Turbo Shower Head 360 Rotated High Pressure Water Save Shower Head High Pressure Water Bathroom Porduct
aliexpress.ru
$33.60
Новинка весна-лето 2023 Y2K Мужская футболка с коротким рукавом и принтом медведя
aliexpress.ru
$40.14
22 Holes Panini Household Takoyaki Machine Electric Takoyaki Maker Octopus Balls Grill Pan Breakfast Machine
aliexpress.com
$6.92
Game Genshin Impact Keqing Large Mouse Pad Mice Mat HD Laptop Decor Tabletop Keyboard Desk Mat Playmat Mousepad Drop shipping
aliexpress.com
$32.06
Куртка с длинным воротником, Отложное пальто, Повседневная однотонная облегающая теплая длинная флисовая верхняя одежда, зимнее женское па...
aliexpress.com
$16.00
Nordic tropical leaves flamingo living room TV sofa background mural custom self-adhesive waterproof wallpaper photos papier
aliexpress.com
$4.66
3Pcs Stainless Steel Ruler Metal Ruler for Engineering School Office Drawing 20cm/30cm/40cm
aliexpress.com
$1.12
Круглый брелок для мам, подвески для ювелирных изделий, украшения для рукоделия, литые инструменты AXYD
aliexpress.com
$6.16
Watch Protective Case Tempered Film One-Piece Case Protective Cover for Iwatch All-Inclusive Diamond Case with Tempered Glass
aliexpress.com
$0.99
50pcs Nail Color Paper Palettes Waterproof Color Palette UV Gel Painting Paper Disposable Glue Paper Manicure Polish Mixing Tray
aliexpress.com
$35.75
high-heeled shoes lady rubber flip flops ladies' slippers slipers women square toe black sandals luxury slides hawaiian 2021 bei
dhgate.com
$691.98
larissa holt "coastal fir"home decor handcrafts /hd print oil painting on canvas wall art canvas pictures 7231
dhgate.com
$18.89
его a beautiful day to leave me alone женщины tshirt хлопок повседневный смешные t рубашка lady yong девочка top tee s, White
dhgate.com
$0.16
74pcs baby girl boy baptism party balloon garland arch ballon blanc birthday baby shower gender reveal christening decoration xn wmtnhz
dhgate.com
$10.11
NS18 Silicone Led Magnet Band Combo of 4 Orange, Red, Green And Brown Watch - For Boys & Girls
flipkart.com
$10.11
NS18 Vintage Butterfly Rakhi Combo of 4 Pink, Red, Black And Green Watch - For Women
flipkart.com
$19.24
Snoogg Pack Of 2 Yellow Dried Leaves Combo Tote Shopping Grocery Bag With Coin Pencil Purse Shoulder Bag(Multicolor, 5 L)
flipkart.com















